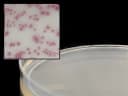
HardyCHROM UTI Agar Plates - Rapid UTI Pathogen ID

HardyCHROM™ Chromogenic Agar Plates for UTI Detection - Hardy Diagnostics
USAMP#16893114SKU: G313HardyCHROM™



Product Spotlight
- Efficiently identifies and differentiates urinary tract infection (UTI) pathogens through color changes, simplifying initial urine specimen analysis.
- Incorporates specialized chromogenic substrates that react with microbial enzymes, producing distinct colors for easy organism identification, minimizing the need for extensive confirmatory testing.
- Optimized for clinical laboratories, these prepared media plates support the cultivation and differentiation of a wide range of bacteria involved in UTIs.
- Designed for accuracy and ease of use, HardyCHROM™ UTI plates are a crucial tool in rapid UTI diagnosis and management.